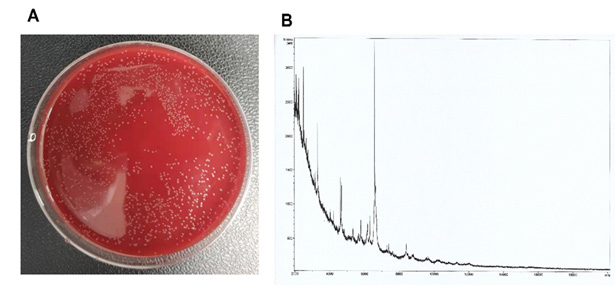

Research Article
Creative Commons, CC-BY
Synergistic Effect of Vancomycin and The Complex of Di-Decanohydroxamato-Iron (III) Chloride Against Corynebacterium Kroppenstedtii
*Corresponding author: Rongshan Li, Department of Nephrology, Fifth Hospital of Shanxi Medical University (Shanxi Provincial People’s Hospital), Shanxi Kidney Disease Institute, China.
Received: December 16, 2024; Published: January 07, 2025
DOI: 10.34297/AJBSR.2025.25.003316
Abstract
The aim of this study was to extend our investigations into the antibacterial properties of iron (III) complexes of aliphatic hydroxamic acids in synergy with vancomycin. We studied the effects of vancomycin combined with the di-decanohydroxamato iron (III) chloride complex (HA10Fe3Cl) against Corynebacterium kroppenstedtii (C. kroppenstedtii). The Minimum Inhibitory Concentration (MIC) of vancomycin, complex HA10Fe3Cl and their combination was determined using a microdilution drug susceptibility test. The MIC for the combination of vancomycin and complex HA10Fe3Cl was lower than the MIC observed for vancomycin or complex HA10Fe3Cl alone. The combination of vancomycin and complex HA10Fe3Cl has a strong inhibitory effect against the growth of C. kroppenstedtii It would be interesting to further investigate the synergistic effect of vancomycin-complex HA10Fe3Cl combination in order to elucidate the mechanism against C. kroppenstedtii. Our results provide a new pathway for the development and enhancement of strategies for the clinical treatment of infections caused by C. kroppenstedtii.
Keywords: Vancomycin, Di-decanohydroxamato iron (III) chloride, Drug susceptibility assay, Corynebacterium kroppenstedtii
Introduction
Granulomatous Lobular Mastitis (GLM) is a chronic inflammatory disease that primarily affects the lobules of the mammary gland, characterized by the formation of granulomas within breast tissue. Clinically, this condition is recognized as GLM [1]. In recent years, there has been a notable increase in the incidence of GLM among postpartum women of childbearing age, presenting as a chronic focal inflammatory disorder [2]. The pathogenesis of GLM is thought to involve several factors, including autoimmune reactions, hyper-sensitivity to breast milk, local trauma, and microbial infections. Notably, some studies have linked granulomatous mastitis to infections with Corynebacterium kroppenstedtii (C. kroppenstedtii) [3,4]. C. kroppenstedtii is an uncommon Gram-positive, short rod-shaped bacillus that poses challenges for culture in conventional media after 48 hours due to its lack of characteristic mycolic acid branching [5,6]. It grows more effectively on blood agar plates supplemented with Tween 80 [7,8]. The lipophilicity of C. kroppenstedtii is considered a key pathogenic trait, as fat-rich environments are conducive to its growth; this is particularly relevant given the high fat content of mammary tissues, which predisposes postpartum women to infections by this bacterium. No clear guidelines are present on how to approach a patient with idiopathic granulomatous mastitis and many treatment options have been tried in reported cases. Some literature suggests that the treatment of breast inflammation associated with C. kroppenstedtii infection may benefit from a triple antibacterial regimen (isoniazid, rifampicin, and ethambutol) or steroid, aiming to target the infection at its source for eradication [9-11]. Some scholar also recommends using antibiotics, the most used were doxycycline, amoxicillin (with and without clavulanic acid), ciprofloxacin and cefuroxime, and in some cases, tetracycline was used with favourable outcomes [12-15].
While anti-tuberculosis medications show promise in managing refractory chronic granulomatous mastitis, it is essential to obtain a pathological diagnosis before initiating treatment. Attention must also be paid to the side effects associated with these drugs [16]. Given the prolonged treatment duration, high dosages, and combination therapy often required, adverse reactions frequently arise. Drug-induced liver damage is the most prevalent issue, potentially leading to severe complications such as liver failure, which can be fatal [16]. Interestingly, our previous work demonstrated that the hydroxamic acids and their iron (II/III) complexes displayed the antibacterial or antifungal activity [17] and anti-mycobacterial activity [18]. In the present study, we aim to investigate the effects of the complex of di-decanohydroxamato-iron (III) chloride (HA10Fe3Cl) (Figure 1) against the growth of C. kroppenstedtii, specifically assessing the Minimal Inhibitory Concentration (MIC). Furthermore, we also evaluate the potential clinical utility of the complex HA10Fe3Cl in conjunction with vancomycin as a treatment strategy for C. kroppenstedtii infections, thus contributing to the development of new therapeutic approaches.
Materials and Methods
Materials
The bacteria C. kroppenstedtii were provided by the microbiology laboratory of the laboratory department of Shanxi Provincial People’s Hospital. The complex HA10Fe3Cl obtained from N-hydroxydecanamide acid (HA10) (Figure 1) were synthesized in microbiology, bioorganic and macromolecular chemistry unit, Faculty of Pharmacy, Université libre de Bruxelles (ULB), Belgium. The mainly regents used in the present study included: Lysed horse serum (OXOID), M-H broth medium (Qingdao Hai Bo), CAMHB broth medium (Qingdao Hai Bo), Methyl Thiazolyl Tetrazolium (MTT, Nanjing Diensel Biotechnology Co., Ltd.), vancomycin (Solebo Bio), formic acid (Sigma Aldrich), α-Cyano-4-hydroxycinnamic acid (HCCA) (Sigma Aldrich). The main equipment was Biosafety cabinet (HFsafe-1500TE), CO₂ thermostatic incubator (35±2°C, GHP- 9050), VITEK turbidimeter (WZB-175), Bruker MALDI Biotyper (MBT), Smart MALDI-TOF MS instrument (Bruker Daltonics).
Methods
Synthetic Method of Iron (III) Complex of Hydroxamic Acid: The synthetic method for the complex of di-decanohydroxamato- iron (III) chloride (HA10Fe3Cl) starting from of the N-hydroxydecanamide (HA10) and their characterization by Infra-Red (IR), Ultra-Violet (UV) spectroscopy, magnetic susceptibility measurement, molar conductivity, Karl Fischer titration, chloride ions identification, mass spectrometry, Electron Paramagnetic Resonance (EPR) spectroscopy, partition coefficient (logP) determination, stability study and elemental analysis were reported in our previous work [17].
Bacteria Isolation and Identification: The C. kroppenstedtii strain used in this study was isolated from the breast pus in a 38-year-old patient suffering from mastitis, and the breast pus was inoculated into a blood agar medium and incubated for 24-48 hours at 37°C in 5% CO2 environment. The individual colonies were picked for MALDI-TOF mass spectrometry identification. Briefly, fresh colony was transferred onto an MALDI Biotyper (MBT) Biotarget 96 (Bruker Daltonics) target site using a sterile wooden toothpick, overlaid with 1 μL of 70% (v/v) formic acid in High Performance Liquid Chromatography (HPLC) grade water, and allowed to dry air at room temperature. Once dry, 1 μL of α-Cyano-4-hydroxycinnamic acid (HCCA) matrix solution (10 mg/mL) was applied and allowed to dry once more before loading sample targets into the Matrix Assisted Laser Desorption Ionization - Time of Flight Mass spectrometry (MALDI-TOF MS) instrument for analysis. Sample mass spectra were obtained on a Bruker MBT Smart MALDI-TOF MS instrument (Bruker Daltonics) set to detect a molecular mass range of 2 to 20 kDa with a laser frequency of 200 Hz. Bruker flexControl (version 3.4) and MBT Compass (version 4.1) software programs were used for automated instrument control and data acquisition, respectively. Species-level sample identities were determined by the MTB software searching against the Bruker BDAL MSP library database (RUO version 9). Samples with Biotyper ID scores ≥ 1.70 were accepted for identification, while ID scores <1.70 were considered unreliable and those samples were excluded from analyses. This cutoff score has been used previously, in conjunction with the formic acid overlay method, for identification of anaerobic bacterial isolates [19].
Preparation of Bacterial Suspension: A small amount C. kroppenstedtii preculture was inoculated and grown in blood agar medium plate at 37°C incubation. The next day, fresh single colonies were picked using a sterile cotton swab and mixed in a sterile 3 mL tube of 0.45% sodium chloride (v/v) (NaCl), which was adjusted to a McFarland turbidity of 0.5, corresponding to 1.5×108 CFU/mL. Then, 30 μL of bacterial suspension was added to 3 mL of M-H culture medium as the inoculum for further experiment.
Colony Forming Unit (CFU)Determination of Inoculum: The inoculum was diluted with 10 times serial dilution in M-H culture medium. Spread 100 μL of each dilution on blood agar plates and incubate in a CO₂ incubator for 24 hours. Calculate the average number of colonies for each dilution using the following equation.

Here, Nc=Number of colonies, Df = Dilution Factor, Vc= Volume of the culture plate (mL).
Minimal Inhibitory Concentration (MIC) Determination: The MIC determination was performed using the microdilution method on 96-well plate. Briefly, the 20 μL vancomycin (5 mg/mL) or complexe HA10Fe3Cl (5 mg/mL) was injected into 180 μL MH medium with 10 times dilution, then transfer 100 μL mixture into the next well with 100 μL MH medium, and so on. The final volume for drug dilutions were 100 μL. Then inoculate 100 μL were injected into each well. The wells contained only drugs or bacterial inoculum were considered as the controls. The final volume of each well was 200 μL and the wells without bacterial inoculum. The plate was incubated in CO2 incubator for 24 h.
The combined effect of vancomycin and the complex HA10Fe3Cl was also performed using a microdilution method. We firstly fixed the vancomycin concentration, serial diluted complex HA10Fe3Cl or fixed the complex HA10Fe3Cl concentration, serial diluted vancomycin, then adding the same bacterial inoculum. The plate was incubated in CO2 incubator for 24 h. After that, 30 μL of MTT (5 mg/ mL, m/v) was added to each well and incubated in CO2 incubator for 30-60 min. The results were observed by color changes. If the color in the wells is less than that in the positive control wells, it is considered that the drug has an inhibitory effect on the growth of the bacteria, and the lowest concentration of the drug in the wells is regarded as the lowest inhibitory concentration for the bacteria.
The fractional inhibitory concentration index (FICI) was calculated according to the checkerboard method.

MICa and MICb represent the MIC of the complex HA10Fe3Cl or vancomycin alone. MICab is the MIC of the complex HA10Fe3Cl in combination with a fixed vancomycin concentration. MICba is the MIC of vancomycin in combination with a fixed complex HA10Fe3Cl concentration. The fixed concentrations were 4- and 20-fold lower than the MICa or MICb, respectively. In agreement with the checkerboard method, synergy is reached when the FICI is <0.5 [20].
Results
Identification of C. Kroppenstedtii
Figure 2: The C. kroppenstedtii was grown in blood agar plate (A) and the identification by MALDI-TOF MS (B).
After 24 hours of inoculation with mammary pus, single colonies of bacteria were observed growing on the blood agar plate. These individual colonies were subsequently selected for identification via MALDI-TOF MS, with ID scores of 1.834 (Figure 2).
Bacterial Colony-Forming Units (CFU) Calculation

Figure 3: The C. kroppenstedtii inoculum was grown in a blood agar plate. The 100, 10-1, 10-2, and 10-3 indicated the 10 times serial dilution for inoculum.
The inoculum used in the drug sensitivity experiments was diluted in a series of 10-fold dilutions. A volume of 100 μL from each dilution was plated onto blood agar plates, spread evenly, and incubated at 37°C for 24 hours. The CFU of C. kroppenstedtii per mL were 2.64×105 The growth pattern of the colonies is illustrated in (Figure 3).
MIC Determination
After 24h incubation, we observed the color changes in various drug conditions. The positive control of each group showed good bacterial growth, and the negative control showed no bacterial growth. The interference of bacterial solution and culture solution on the experiment was excluded. This indicates that there was no interference from the bacterial or culture solutions during the experiment, confirming that the experimental conditions were standardized, free of contamination, and that the data obtained were valid. The MIC of vancomycin and the complex HA10Fe3Cl were 0.32 μg/mL and 250 μg/mL, respectively.
To investigate whether this growth inhibition results from a synergy between the complex HA10Fe3Cl and vancomycin, the checkerboard method was also used to calculate FICI. The MIC of the complex HA10Fe3Cl dropped from 250 μg/mL to 31.25 μg/mL in the presence of vancomycin (0.2 μg/mL), and the MIC of vancomycin dropped from 0.32 μg/mL to 0.08 μg/mL in the presence of the complex HA10Fe3Cl (500 μg/mL), suggesting that the combination can inhibit C. kroppenstedtii, growth in synergy (FICI = 0.375) (Table 1).
Discussion
The incidence of GLM has been rising annually among postpartum women of childbearing age, prompting increasing research into its etiology both domestically and internationally. Various theories have been proposed regarding its causes, including autoimmune reactions, hypersensitivity to breast milk, use of oral contraceptive pills, local trauma, and microbial infections. Among these, C. kroppenstedtii is considered as one of the pathogeneses for GLM.
C. kroppenstedtii, with its lipophilic properties, is frequently implicated in infections localized in fat-rich tissues, such as the bloodstream, heart valves, and catheter sites [21]. Numerous studies suggest that C. kroppenstedtii plays a significant role in the pathogenesis of Chronic Lactational Mastitis (CLM) due to its unique structural characteristics [21]. Closely related taxonomically to Mycobacterium, it shares morphological similarities with Mycobacterium tuberculosis and exhibits intracellular parasitism, primarily surviving in neutrophil-infiltrated lipid vacuoles within granulation tissue rather than in inflamed tissue. Consequently, only drugs with high lipophilicity and extensive volume of distribution can effectively inhibit bacterial growth in this specific environment [22].
Infections caused by C. kroppenstedtii are marked by granulomatous inflammation, abscess formation, and potential progression to sinus tracts or fistulas. This complicates treatment, often resulting in invasive procedures, increased risk of breast contour disruption, and, in severe cases, mastectomy to prevent recurrent disease. Conventional treatments, typically involving immunosuppressive drugs, can be lengthy, fail to completely eliminate inflammatory lesions, and are prone to repeated relapses. Thus, exploring an effective therapeutic protocol that minimizes patient harm is critical. In this study, we investigated the efficacy of vancomycin combined with a novel antimicrobial agent, the complex HA10Fe- 3Cl, in vitro experiments against C. kroppenstedtii.
Our findings indicated that the MIC of vancomycin alone for C. kroppenstedtii was approximately 0.32 μg/mL, while that of the complex HA10Fe3Cl was 250 μg/mL. When these two agents were used in combination, fixing the concentration of vancomycin at 0.2 μg/mL resulted in an MIC for the complex HA10Fe3Cl of 31.25 μg/ mL, demonstrating a reduced MIC compared to when the agent was administered alone. Conversely, fixing the concentration of the complex HA10Fe3Cl at 500 μg/mL led to a decrease in the MIC of vancomycin to 0.08 μg/mL, indicating enhanced effectiveness of the combination therapy over monotherapy. Given the variability in pathogenic bacterial loads and individual immune responses, clinical dosages should be adjusted according to patient symptoms and drug sensitivity tests.
Indeed, our previously study also demonstrated that the complex HA10Fe3Cl displayed the inhibition effect against mycobacteria, including M. tuberculosis, M. bovis BCG and M, marinum and the combination of vancomycin and complex HA10Fe3Cl possess the synergistic effect against M. bovis BCG [18]. Further investigation showed that the targets of the complex HA10Fe3Cl mainly affect the compounds related to the integrity of the mycobacterial cell wall. Therefore, our present study indicated that the inhibitory effect against C. kroppenstedtii could also influence the cell wall compounds biosynthesis. However, with the appearance of the drug resistance strain, especially resistance to erythromycin and clindamycin, ciprofloxacin, tetracycline, and trimethoprim-sulfamethoxazole [23], it is urgent to develop novel regiment to fight against C. kroppenstedtii infection. The genes erm(X) in clindamycin and erythromycin-resistant, and genes sul(1) in trimethoprim sulfamethoxazole- resistant, and gene tet(W) in tetracycline-resistant were also identified in clinical strains [23]. Until now, there have been few reports about resistance to rifampicin, linezolid, vancomycin, or gentamicin. Our study also provides a novel therapeutic regimen using drug combination for C. kroppenstedtii infection.
Conclusion
The antibacterial activity of vancomycin and the complex HA10Fe3Cl is increased when they are used in combination against C. kroppenstedtii (Table 1). The results show that an inhibitory effect is enhanced when two antibacterial compounds are in combination. This synergy between vancomycin and the complex HA10Fe3Cl is promising for the development of new antibacterial agents to treat the infections caused by C. kroppenstedtii.
Conflict of Interest
The authors declare no conflicts of interest. The authors declare that the research was conducted in the absence of any commercial or financial relationships that could be construed as a potential conflict of interest.
Acknowledgements
None.
References
- X Q Li, H L Wu, J P Yuan, T gang Liu, S R Sun, C Chen (2020) Bacteria Associated with Granulomatous Lobular Mastitis and the Potential for Personalized Therapy. J Investig Surg 35(1): 164-170.
- M Zhang, D Pu, D Feng, G Shi, J Li (2024) Rare and Complicated Granulomatous Lobular Mastitis (2000–2023): A Bibliometrics Study and Visualization Analysis. J Inflamm Res 17: 3709-3724.
- S B Li, Q Huang, P P Song, X R Han, Z Y Liu, L Zhou, et al. (2023) Clinical characteristics and therapeutic strategy of granulomatous mastitis accompanied by Corynebacterium kroppenstedtii: a retrospective cohort study. BMC Womens Health 23(1): 388-395.
- G Taylor, S Paviour, S Musaad, W Jones, D Holland (2003) A clinicopathological review of 34 cases of inflammatory breast disease showing an association between corynebacteria infection and granulomatous mastitis. Pathology 35(2): 109-119.
- N Sanchez Eluchans, C Barberis, R Cittadini, A M Ozuna Villca, M F Veiga, V Vilches, et al. (2021) Corynebacterium kroppenstedtii breast infections: Report of four cases. Rev Argent Microbiol 53(4): 304-308.
- X Meniche, C Labarre, C De Sousa D Auria, E Huc, F Laval, M Tropis, et al. (2009) Identification of a stress-induced factor of Corynebacterineae that is involved in the regulation of the outer membrane lipid composition. J Bacteriol 191(23): 7323-7332.
- S C Y Wong, R W S Poon, C H Foo, A H Y Ngan, H Tse, V C M Lam, et al. (2018) Novel selective medium for the isolation of Corynebacterium kroppenstedtii from heavily colonised clinical specimens. J Clin Pathol 71(9): 781-786.
- P Riegel, P Liégeois, M P Chenard, C Mathelin, H Monteil (2004) Isolations of Corynebacterium kroppenstedtii from a breast abscess. Int J Med Microbiol 294(6): 413-416.
- A Akcan, H Akyildiz, M A Deneme, H Akgun, Y Aritas (2006) Granulomatous lobular mastitis: A complex diagnostic and therapeutic problem. World J Surg 30(8): 1403-1409.
- R Sarmadian, F Safi, H Sarmadian, M Shokrpour, A Almasi Hashiani (2024) Treatment modalities for granulomatous mastitis, seeking the most appropriate treatment with the least recurrence rate: a systematic review and meta-analysis. Eur J Med Res 29(1): 164-184.
- J Li, X Sun (2024) Progress in Diagnosis and Treatment of Plasma Cell Mastitis with Traditional Chinese and Western Medicine. Adv Clin Med 14(6): 562-567.
- E Abdalla, A Elmudathir, A H Ahmed, B Ali, M E Ali, N M Taha, et al. (2023) Clindamycin: an Effective Treatment for Granulomatous Mastitis Caused by Corynebacterium kroppenstedtii in a Pregnant Patient. Eur J Case Reports Intern Med.11(1): 1-3.
- I Fernández Natal, D Rodríguez Lázaro, T Marrodán Ciordia, J A Sáez Nieto, S Valdezate, H Rodríguez Pollán, et al. (2016) Characterization and antimicrobial susceptibility of one antibiotic-sensitive and one multidrug-resistant Corynebacterium kroppenstedtii strain isolated from patients with granulomatous mastitis. New Microbes New Infect 14:93-97.
- S Roth, T Ehrlich, H J Schäfers, S L Becker (2020) Late-onset native valve endocarditis caused by Corynebacterium kroppenstedtii. Int J Infect Dis 101: 1-3.
- F Shojaeian, S Haghighat, F Abbasvandi, A Houshdar Tehrani, N Najar Najafi, A Zandi, et al. (2024) Refractory and Recurrent Idiopathic Granulomatous Mastitis Treatment: Adaptive, Randomized Clinical Trial. J Am Coll Surgeons 238(6): 1153-1165.
- V A Dartois, E J Rubin (2022) Anti-tuberculosis treatment strategies and drug development: challenges and priorities. Nat Rev Microbiol 20(11): 685-701.
- I S Sow, M Gelbcke, F Meyer, M Vandeput, M Marloye, S Basov, et al. (2023) Synthesis and biological activity of iron (II), iron (III), nickel (II), copper (II) and zinc (II) complexes of aliphatic hydroxamic acids. J Coord Chem 76(1): 76-105.
- D Yang, Y Zhang, I S Sow, H Liang, N El Manssouri, M Gelbcke, et al. (2023) Antimycobacterial Activities of Hydroxamic Acids and Their Iron (II/III), Nickel (II), Copper (II) and Zinc (II) Complexes. Microorganisms 11(10): 2611-2622.
- Y M S Hsu, C A D Burnham (2014) MALDI-TOF MS identification of anaerobic bacteria: Assessment of pre-analytical variables and specimen preparation techniques. Diagn Microbiol Infect Dis 79(2): 144-148.
- D Yang, G Vandenbussche, D Vertommen, D Evrard, R Abskharon, J F Cavalier, et al. (2019) Methyl arachidonyl fluorophosphonate inhibits Mycobacterium tuberculosis thioesterase TesA and globally affects vancomycin susceptibility. FEBS Lett 594(1): 79-93.
- A Tauch, I Fernández Natal, F Soriano (2016) A microbiological and clinical review on Corynebacterium kroppenstedtii. Int J Infect Dis 48: 33-39.
- P Brown, O Abdulle, S Boakes, N Divall, E Duperchy, R Lester, et al. (2021) Influence of lipophilicity on the antibacterial activity of polymyxin derivatives and on their ability to act as potentiators of rifampicin. ACS Infect Dis 7(4): 894-905.
- Q Zhang, S Wu, P Song, Y Liu, L Ding, Q Shi, et al. (2023) Antibiotic resistance and resistance mechanism of Corynebacterium kroppenstedtii isolated from patients with mastadenitis. Eur J Clin Microbiol Infect Dis 42(3): 525-528.